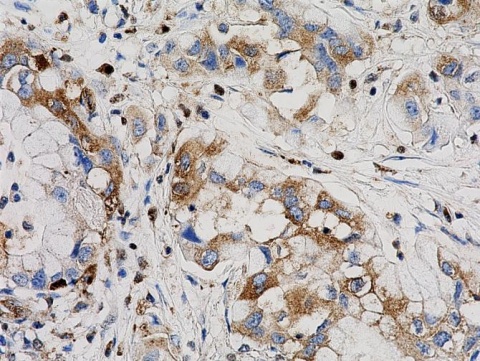

Medicina
Una investigación de la UOC mejora las imágenes médicas obtenidas por TAC
Un equipo internacional liderado desde la UOC (Catalunya, España) ha desarrollado un nuevo método que mejora la calidad de las imágenes obtenidas por tomografía computarizada (TAC), una de las técnicas más usadas para estudiar los efectos de muchas enfermedades como, por ejemplo, a nivel pulmonar del coronavirus. El algoritmo, que se ha puesto a prueba con datos simulados, permite distinguir mejor entre tipos diferentes de tejidos y abre la puerta a reducir la dosis de radiación a la que se someten los pacientes en este tipo de pruebas.
La tomografía computarizada, también conocida como TAC, utiliza procesos computacionales para combinar múltiples mediciones mediante rayos X desde distintos ángulos y así producir imágenes tomográficas. Este proceso no invasivo, que genera una visión reconstruida en tres dimensiones de órganos y tejidos, permite a los médicos ver dentro del cuerpo sin practicar ninguna incisión.
Se trata de una técnica que “ayuda a los expertos a determinar la presencia de tumores y su localización, tamaño y extensión exactos. También se puede usar para diagnosticar trastornos musculares u óseos, infecciones o coágulos sanguíneos, enfermedades del corazón, nódulos pulmonares y masas en el hígado”, explica Mohammad Mahdi Dehshibi, investigador postdoctoral en el Scene Understanding and Artificial Intelligence Laboratory (SUNAI), de los Estudios de Informática, Multimedia y Telecomunicación de la UOC, y director del Pattern Research Centre en Teherán (Irán). “Esta tecnología se encuentra entre las técnicas de imagen más utilizadas para guiar biopsias y terapias de radiación, así como para monitorizar la efectividad de tratamientos para el cáncer y detectar heridas y hemorragias internas”.
Sin embargo, la tomografía computarizada implica el riesgo de dañar la estructura del ADN y, por ende, producir cáncer, a causa de la exposición del cuerpo a los rayos X. Por ejemplo, la radiación que recibe una persona al hacerse un TAC en la cabeza equivale al total de radiación al que se expone el cuerpo a lo largo de 243 días de vida normal.
En busca de formas de reducir esta radiación, el equipo liderado por Mohammad Mahdi Dehshibi ha desarrollado un nuevo algoritmo de postprocesamiento que aumenta la calidad de las imágenes de TAC reconstruidas. Mientras que los métodos convencionales de tomografía computarizada recogen sólo una parte concreta del espectro de energía de los rayos X, los investigadores han probado un rango más amplio de energías, dividido en intervalos, para ganar más contraste. Tras ensayarlo en datos artificiales mediante un software de simulación llamado GATE/GEANT4, hallaron que el algoritmo mejora la calidad y reduce el ruido de las imágenes, lo que permite diferenciar mejor entre tipos de tejidos diferentes con menores dosis de rayos X, según publican en la revista Journal of Information Processing.
“Distinguir entre dos tejidos diferentes en una misma zona, ya sean normales o anormales, es crítico para el plan de tratamiento de los médicos y radiólogos cuando esta decisión implica la vida del paciente”, remarca Dehshibi. “Una mejor discriminación entre tejidos incrementa la probabilidad de éxito de un tratamiento”. El nuevo método aumentó la capacidad de diferenciación entre tejidos en un 60% respecto al TAC convencional en las simulaciones.
“Proponemos una aproximación de postprocesamiento que no requerirá una reconfiguración sustancial del hardware y aportará más libertad a los expertos en técnicas de imagen para futura investigación”, declara el investigador de la UOC. “Esperamos que los resultados de este estudio se puedan examinar más adelante en un entorno clínico para reducir el efecto de la radiación de rayos X”. (Fuente: UOC)